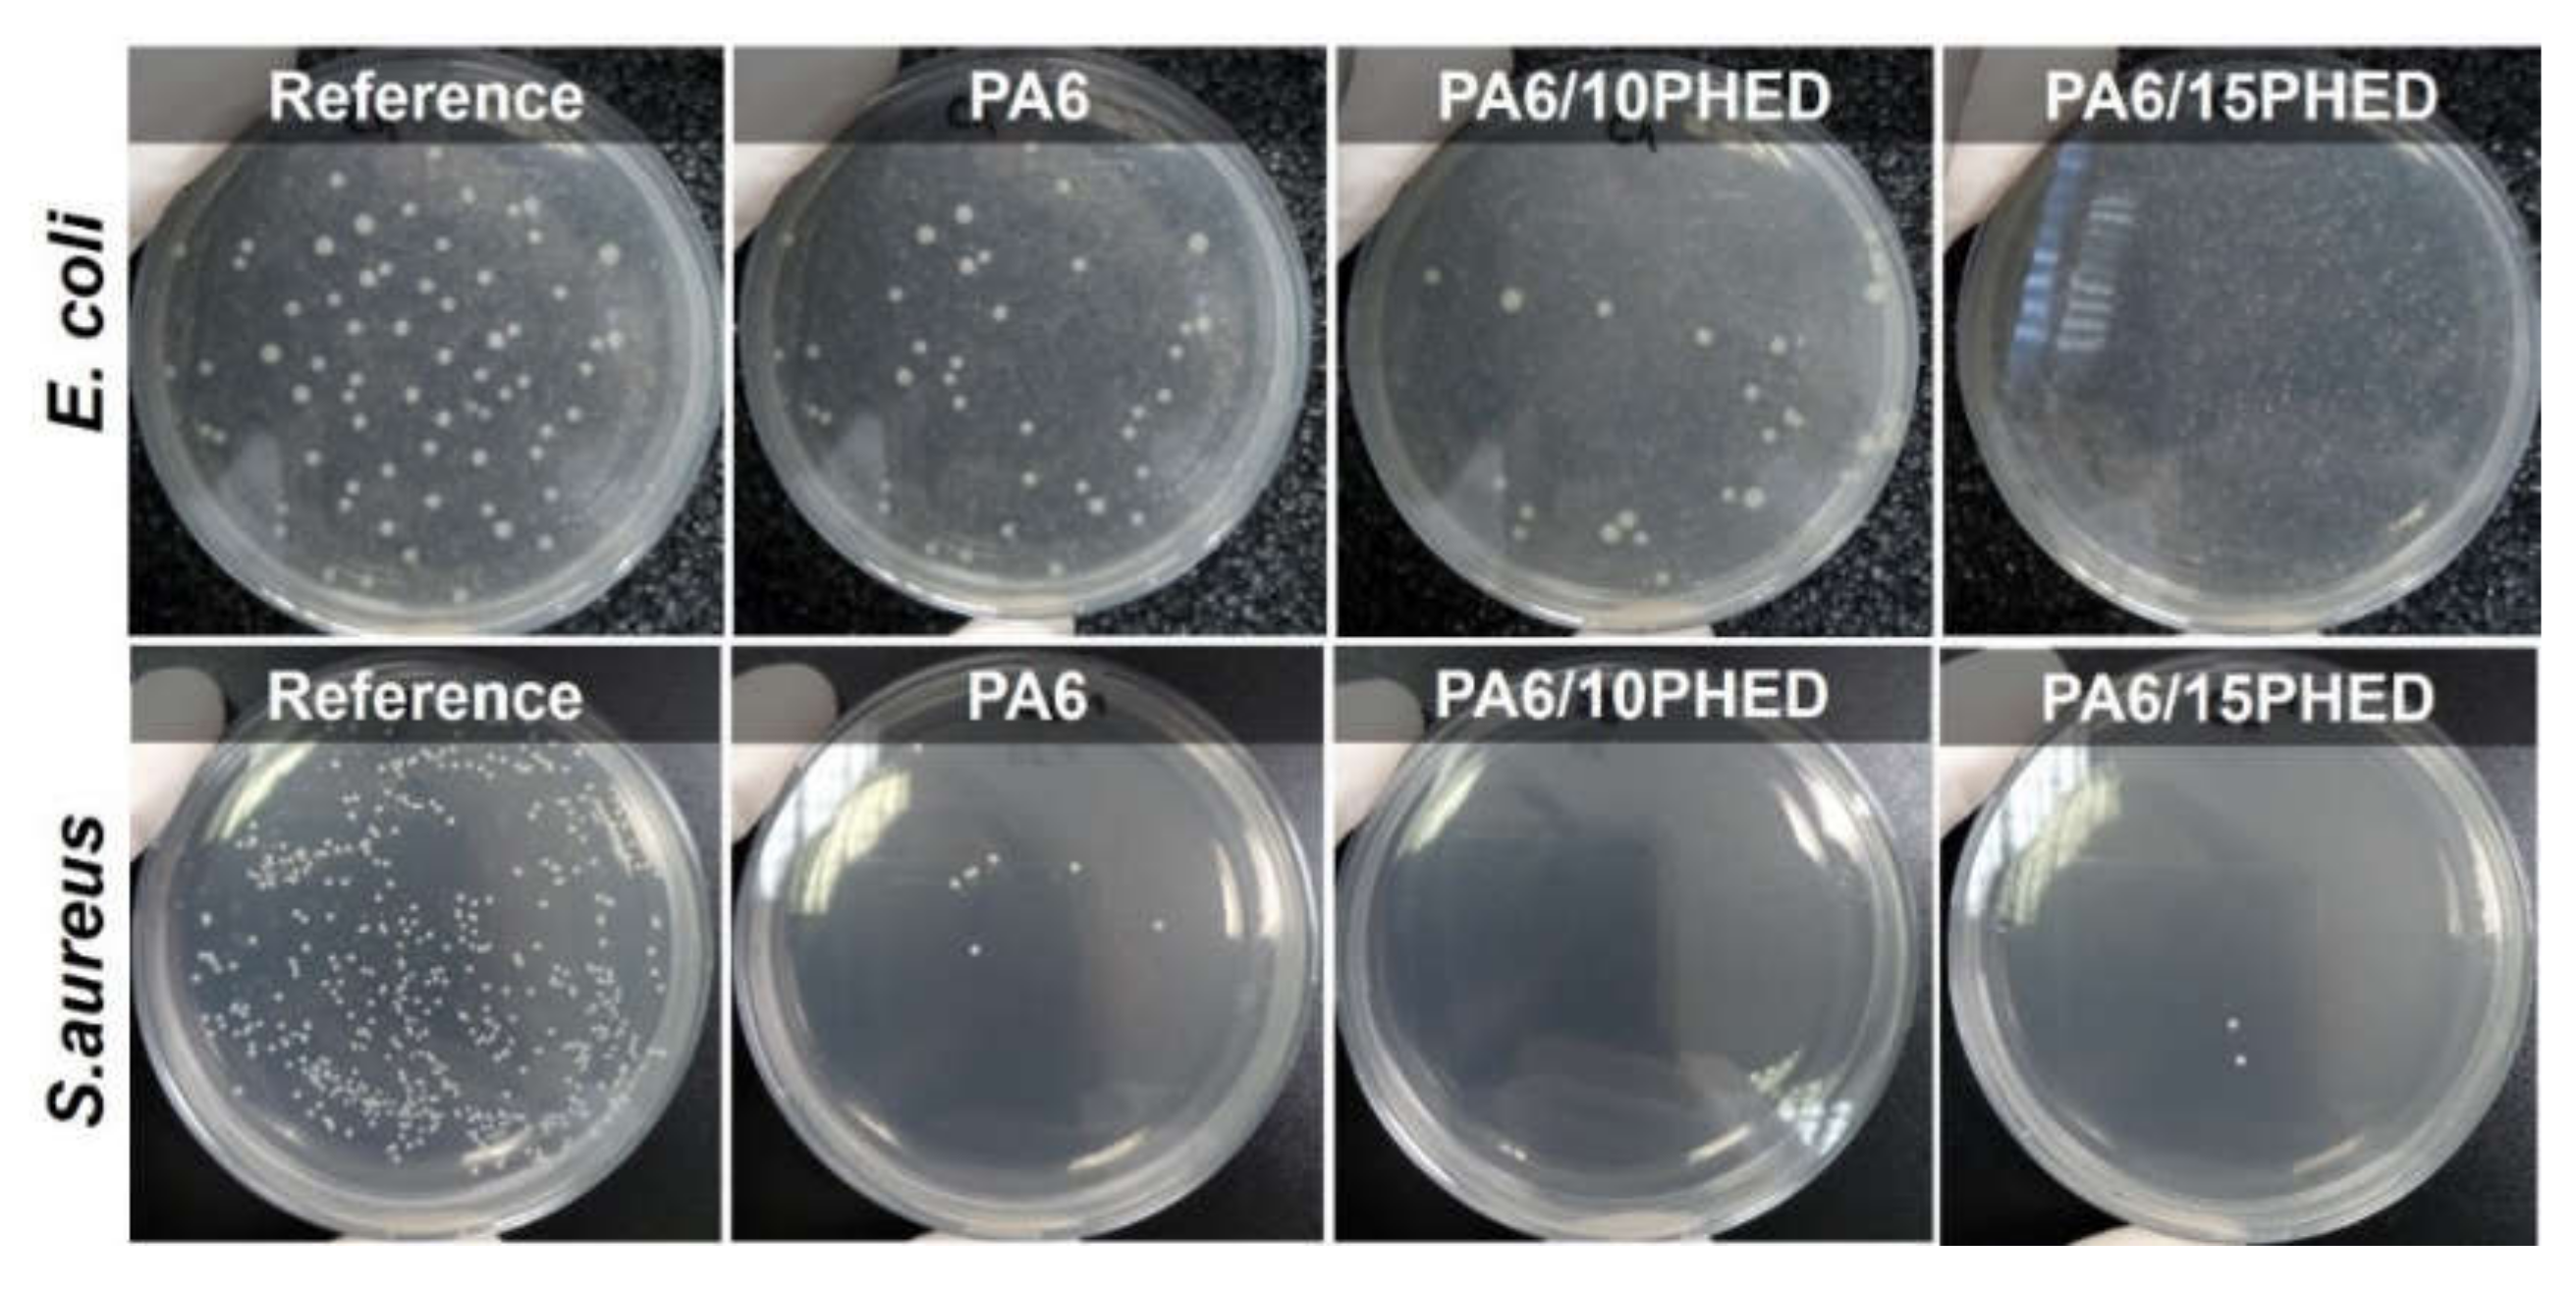
Polymers 13 00905 g003

New Insights into Antibacterial and Antifungal Properties, Cytotoxicity and Aquatic Ecotoxicity of Flame Retardant PA6/DOPO-Derivative Nanocomposite Textile Fibers
Abstract
1. Introduction
2. Materials and Methods
2.1. Materials
2.2. Antibacterial Properties
2.3. Antifungal Properties
2.4. Cytotoxicity
2.5. Leaching Properties
2.5.1. Fibers Properties after Leaching and Washing
2.5.2. Ecotoxicity of Leachates
3. Results and Discussion
3.1. Antibacterial and Antifungal Properties
3.2. Cytotoxicity Properties
3.3. Leaching Properties
4. Conclusions
Supplementary Materials
Author Contributions
Funding
Institutional Review Board Statement
Informed Consent Statement
Data Availability Statement
Conflicts of Interest
References
- Morgan, A.B. The Future of Flame Retardant Polymers—Unmet Needs and Likely New Approaches. Polym. Rev. 2019, 59, 25–54. [Google Scholar] [CrossRef]
- Velencoso, M.M.; Battig, A.; Markwart, J.C.; Schartel, B.; Wurm, F.R. Molecular Firefighting—How Modern Phosphorus Chemistry Can Help Solve the Challenge of Flame Retardancy. Angew. Chem. Int. Ed. 2018, 57, 10450–10467. [Google Scholar] [CrossRef] [PubMed]
- Ohajinwa, C.M.; Van Bodegom, P.M.; Xie, Q.; Chen, J.; Vijver, M.G.; Osibanjo, O.O.; Peijnenburg, W.J. Hydrophobic Organic Pollutants in Soils and Dusts at Electronic Waste Recycling Sites: Occurrence and Possible Impacts of Polybrominated Diphenyl Ethers. Int. J. Environ. Res. Public Heal. 2019, 16, 360. [Google Scholar] [CrossRef]
- Deng, Y.; Zhang, Y.; Qiao, R.; Bonilla, M.M.; Yang, X.; Ren, H.; Lemos, B. Evidence that microplastics aggravate the toxicity of organophosphorus flame retardants in mice (Mus musculus). J. Hazard. Mater. 2018, 357, 348–354. [Google Scholar] [CrossRef]
- Simonetti, G.; Di Filippo, P.; Riccardi, C.; Pomata, D.; Sonego, E.; Buiarelli, F. Occurrence of Halogenated Pollutants in Domestic and Occupational Indoor Dust. Int. J. Environ. Res. Public Heal. 2020, 17, 3813. [Google Scholar] [CrossRef]
- La Guardia, M.J.; Schreder, E.D.; Uding, N.; Hale, R.C. Human Indoor Exposure to Airborne Halogenated Flame Retardants: Influence of Airborne Particle Size. Int. J. Environ. Res. Public Heal. 2017, 14, 507. [Google Scholar] [CrossRef] [PubMed]
- Sala, B.; Giménez, J.; De Stephanis, R.; Barceló, D.; Eljarrat, E. First determination of high levels of organophosphorus flame retardants and plasticizers in dolphins from Southern European waters. Environ. Res. 2019, 172, 289–295. [Google Scholar] [CrossRef]
- Barhoumi, B.; Tedetti, M.; Peris, A.; Guigue, C.; Aznar-Alemany, Ò.; Touil, S.; Driss, M.R.; Eljarrat, E. Halogenated flame retardants in atmospheric particles from a North African coastal city (Bizerte, Tunisia): Pollution characteristics and human exposure. Atmospheric Pollut. Res. 2020, 11, 831–840. [Google Scholar] [CrossRef]
- De La Torre, A.; Navarro, I.; Sanz, P.; Martínez, M.D.L. Ángeles Organophosphate compounds, polybrominated diphenyl ethers and novel brominated flame retardants in European indoor house dust: Use, evidence for replacements and assessment of human exposure. J. Hazard. Mater. 2020, 382, 121009. [Google Scholar] [CrossRef]
- Ekpe, O.D.; Choo, G.; Barceló, D.; Oh, J.-E. Introduction of Emerging Halogenated Flame Retardants in the Environment; Elsevier BV: Amsterdam, The Netherlands, 2020; pp. 1–39. [Google Scholar]
- Wendels, S.; Chavez, T.; Bonnet, M.; Salmeia, K.A.; Gaan, S. Recent Developments in Organophosphorus Flame Retardants Containing P-C Bond and Their Applications. Materials 2017, 10, 784. [Google Scholar] [CrossRef] [PubMed]
- Guo, W.; Yu, B.; Yuan, Y.; Song, L.; Hu, Y. In situ preparation of reduced graphene oxide/DOPO-based phosphonamidate hybrids towards high-performance epoxy nanocomposites. Compos. Part B: Eng. 2017, 123, 154–164. [Google Scholar] [CrossRef]
- Hu, W.; Yu, B.; Jiang, S.-D.; Song, L.; Hu, Y.; Wang, B. Hyper-branched polymer grafting graphene oxide as an effective flame retardant and smoke suppressant for polystyrene. J. Hazard. Mater. 2015, 300, 58–66. [Google Scholar] [CrossRef] [PubMed]
- Liu, K.; Li, Y.; Tao, L.; Liu, C.; Xiao, R. Synthesis and characterization of inherently flame retardant polyamide 6 based on a phosphine oxide derivative. Polym. Degrad. Stab. 2019, 163, 151–160. [Google Scholar] [CrossRef]
- Mincheva, R.; Guemiza, H.; Hidan, C.; Moins, S.; Coulembier, O.; Dubois, P.; Laoutid, F. Development of Inherently Flame—Retardant Phosphorylated PLA by Combination of Ring-Opening Polymerization and Reactive Extrusion. Mater. 2019, 13, 13. [Google Scholar] [CrossRef]
- Mourgas, G.; Giebel, E.; Schneck, T.; Unold, J.; Buchmeiser, M.R. Syntheses of intrinsically flame-retardant polyamide 6 fibers and fabrics. J. Appl. Polym. Sci. 2019, 136, 47829. [Google Scholar] [CrossRef]
- Schmidt, C.; Ciesielski, M.; Greiner, L.; Döring, M. Novel organophosphorus flame retardants and their synergistic application in novolac epoxy resin. Polym. Degrad. Stab. 2018, 158, 190–201. [Google Scholar] [CrossRef]
- Shi, Y.; Yu, B.; Zheng, Y.; Yang, J.; Duan, Z.; Hu, Y. Design of reduced graphene oxide decorated with DOPO-phosphanomidate for enhanced fire safety of epoxy resin. J. Colloid Interface Sci. 2018, 521, 160–171. [Google Scholar] [CrossRef] [PubMed]
- Vasiljević, J.; Čolović, M.; Korošin, N. Čelan; Šobak, M.; Štirn, Žiga; Jerman, I. Effect of Different Flame-Retardant Bridged DOPO Derivatives on Properties of in Situ Produced Fiber-Forming Polyamide 6. Polymers 2020, 12, 657. [Google Scholar] [CrossRef]
- Wang, H.; Wang, S.; Du, X.; Wang, H.; Cheng, X.; Du, Z. Synthesis of a novel flame retardant based on DOPO derivatives and its application in waterborne polyurethane. RSC Adv. 2019, 9, 7411–7419. [Google Scholar] [CrossRef]
- Du, J.; Li, H.; Xu, S.; Zhou, Q.; Jin, M.; Tang, J. A review of organophosphorus flame retardants (OPFRs): Occurrence, bioaccumulation, toxicity, and organism exposure. Environ. Sci. Pollut. Res. 2019, 26, 22126–22136. [Google Scholar] [CrossRef] [PubMed]
- Chokwe, T.B.; Abafe, O.A.; Mbelu, S.P.; Okonkwo, J.O.; Sibali, L.L. A review of sources, fate, levels, toxicity, exposure and transformations of organophosphorus flame-retardants and plasticizers in the environment. Emerg. Contam. 2020, 6, 345–366. [Google Scholar] [CrossRef]
- Chupeau, Z.; Bonvallot, N.; Mercier, F.; Le Bot, B.; Chevrier, C.; Glorennec, P. Organophosphorus Flame Retardants: A Global Review of Indoor Contamination and Human Exposure in Europe and Epidemiological Evidence. Int. J. Environ. Res. Public Heal. 2020, 17, 6713. [Google Scholar] [CrossRef] [PubMed]
- Hou, L.; Jiang, J.; Gan, Z.; Dai, Y.; Yang, P.; Yan, Y.; Ding, S.; Su, S.; Bao, X. Spatial Distribution of Organophosphorus and Brominated Flame Retardants in Surface Water, Sediment, Groundwater, and Wild Fish in Chengdu, China. Arch. Environ. Contam. Toxicol. 2019, 77, 279–290. [Google Scholar] [CrossRef]
- Estill, C.F.; Slone, J.; Mayer, A.; Chen, I.-C.; La Guardia, M.J. Worker exposure to flame retardants in manufacturing, construction and service industries. Environ. Int. 2020, 135, 105349. [Google Scholar] [CrossRef] [PubMed]
- Li, J.; Zhao, L.; Letcher, R.J.; Zhang, Y.; Jian, K.; Zhang, J.; Su, G. A review on organophosphate Ester (OPE) flame retardants and plasticizers in foodstuffs: Levels, distribution, human dietary exposure, and future directions. Environ. Int. 2019, 127, 35–51. [Google Scholar] [CrossRef]
- Zhao, H.; Liu, L.; Li, Y.; Zhao, F.; Zhang, S.; Mu, D.; Liu, J.; An, L.; Wan, Y.; Hu, J. Occurrence, Bioaccumulation, and Trophic Transfer of Oligomeric Organophosphorus Flame Retardants in an Aquatic Environment. Environ. Sci. Technol. Lett. 2019, 6, 323–328. [Google Scholar] [CrossRef]
- Blum, A.; Behl, M.; Birnbaum, L.S.; Diamond, M.L.; Phillips, A.; Singla, V.; Sipes, N.S.; Stapleton, H.M.; Venier, M. Organophosphate Ester Flame Retardants: Are They a Regrettable Substitution for Polybrominated Diphenyl Ethers? Environ. Sci. Technol. Lett. 2019, 6, 638–649. [Google Scholar] [CrossRef] [PubMed]
- Fest, C.; Schmidt, K.-J. The Chemistry of Organophosphorus Pesticides; Springer: Berlin, Germany, 1982. [Google Scholar] [CrossRef]
- Salmeia, K.A.; Gaan, S. An overview of some recent advances in DOPO-derivatives: Chemistry and flame retardant applications. Polym. Degrad. Stab. 2015, 113, 119–134. [Google Scholar] [CrossRef]
- Vasiljević, J.; Čolović, M.; Jerman, I.; Simončič, B.; Demšar, A.; Samaki, Y.; Šobak, M.; Šest, E.; Golja, B.; Leskovšek, M.; et al. In situ prepared polyamide 6/DOPO-derivative nanocomposite for melt-spinning of flame retardant textile filaments. Polym. Degrad. Stab. 2019, 166, 50–59. [Google Scholar] [CrossRef]
- Kim, I.J.; Ko, J.W.; Song, M.S.; Cheon, J.W.; Lee, D.J.; Park, J.W.; Yu, S.; Lee, J.H. Thermal and Flame Retardant Properties of Phosphate-Functionalized Silica/Epoxy Nanocomposites. Materials 2020, 13, 5418. [Google Scholar] [CrossRef]
- Wang, J.; Xu, B.; Wang, X.; Liu, Y. A phosphorous-based bi-functional flame retardant for rigid polyurethane foam. Polym. Degrad. Stab. 2021, 186, 109516. [Google Scholar] [CrossRef]
- Hirsch, C.; Striegl, B.; Mathes, S.; Adlhart, C.; Edelmann, M.; Bono, E.; Gaan, S.; Salmeia, K.A.; Hoelting, L.; Krebs, A.; et al. Multiparameter toxicity assessment of novel DOPO-derived organophosphorus flame retardants. Arch. Toxicol. 2017, 91, 407–425. [Google Scholar] [CrossRef] [PubMed]
- Saito, T. Cyclic Organophosphorus Compounds and Process for Making Same. U.S. Patent US3702878A, 14 November 1972. [Google Scholar]
- Kim, S.K.; Lee, I.S.; Seo, S.H.; Choi, S.H. Synthesis of Phosphoric Polymer Coating Solution with Antimicrobial Activity and Flame Retardant Efficiency. Polym. Korea 2011, 35, 431–437. [Google Scholar] [CrossRef]
- Vasiljević, J.; Zorko, M.; Štular, D.; Tomšič, B.; Jerman, I.; Orel, B.; Medved, J.; Kovač, J.; Simončič, B. Structural optimisation of a multifunctional water- and oil-repellent, antibacterial, and flame-retardant sol–gel coating on cellulose fibres. Cellulose 2017, 24, 1511–1528. [Google Scholar] [CrossRef]
- Horrocks, A. Technical fibres for heat and flame protection. In Handbook of Technical Textiles; Elsevier BV: Amsterdam, The Netherlands, 2016; pp. 237–270. [Google Scholar]
- Balasubramaniam, B.; Prateek; Ranjan, S.; Saraf, M.; Kar, P.; Singh, S.P.; Thakur, V.K.; Singh, A.; Gupta, R.K. Antibacterial and Antiviral Functional Materials: Chemistry and Biological Activity toward Tackling COVID-19-like Pandemics. ACS Pharmacol. Transl. Sci. 2021, 4, 8–54. [Google Scholar] [CrossRef] [PubMed]
- Vihodceva, S.; Ramata-Stunda, A.; Pumpure, A. Evaluation of dermal toxicity of antibacterial cotton textile coated by sol-gel technology. J. Text. Inst. 2017, 109, 961–966. [Google Scholar] [CrossRef]
- Štular, D.; Jerman, I.; Simončič, B.; Grgić, K.; Tomšič, B. Influence of the structure of a bio-barrier forming agent on the stimuli-response and antimicrobial activity of a “smart” non-cytotoxic cotton fabric. Cellulose 2018, 25, 6231–6245. [Google Scholar] [CrossRef]
- Almroth, B.C.; Cartine, J.; Jönander, C.; Karlsson, M.; Langlois, J.; Lindström, M.; Lundin, J.; Melander, N.; Pesqueda, A.; Rahmqvist, I.; et al. Assessing the effects of textile leachates in fish using multiple testing methods: From gene expression to behavior. Ecotoxicol. Environ. Saf. 2021, 207, 111523. [Google Scholar] [CrossRef] [PubMed]
- Rajendran, S.; Anand, S.; Rigby, A. Textiles for healthcare and medical applications. In Handbook of Technical Textiles; Elsevier BV: Amsterdam, The Netherlands, 2016; pp. 135–168. [Google Scholar]
- Sun, G. Antimicrobial Textiles; Woodhead Publishing: Cambridge, UK, 2016. [Google Scholar]
- Malis, D.; Jeršek, B.; Tomšič, B.; Štular, D.; Golja, B.; Kapun, G.; Simončič, B. Antibacterial Activity and Biodegradation of Cellulose Fiber Blends with Incorporated ZnO. Materials 2019, 12, 3399. [Google Scholar] [CrossRef]
- Mirjalili, M.; Mohammadi, M.; Karimi, L. Effect of Zinc Oxide Nanoparticles and Sodium Hydroxide on the Self-Cleaning and Antibacterial Properties of Polyethylene Terephthalate. Tekstilec 2017, 60, 269–274. [Google Scholar] [CrossRef]
- Yao, Q.; Zhou, H.; Zhang, W.W.; Cao, W.H.; Liu, Z.X.; Xu, Z. DOPO Derivatives As Well As Preparation Method and Application Thereof. CN104086593, 8 October 2014. [Google Scholar]
- Soroldoni, S.; Martins, S.E.; Castro, I.B.; Pinho, G.L.L. Potential ecotoxicity of metals leached from antifouling paint particles under different salinities. Ecotoxicol. Environ. Saf. 2018, 148, 447–452. [Google Scholar] [CrossRef] [PubMed]
- Kalčíková, G.; Marolt, G.; Kokalj, A.J.; Gotvajn, A.Z. The use of multiwell culture plates in the duckweed toxicity test—A case study on Zn nanoparticles. New Biotechnol. 2018, 47, 67–72. [Google Scholar] [CrossRef] [PubMed]
- Jerman, I.; Čolović, M.; Vasiljević, J.; Simončič, B.; Šehić, A.; Demšar, A. Method for the Preparation of a Polyamide 6 Copolymer and Filaments, Flame Retardant Polyamide 6 Copolymer and Copolymer Filaments. EP3587471A1, 1 January 2020. [Google Scholar]
- Haase, H.; Jordan, L.; Keitel, L.; Keil, C.; Mahltig, B. Comparison of methods for determining the effectiveness of antibacterial functionalized textiles. PLoS ONE 2017, 12, e0188304. [Google Scholar] [CrossRef] [PubMed]
- Hanczvikkel, A.; Víg, A.; Tóth, Á. Survival capability of healthcare-associated, multidrug-resistant bacteria on untreated and on antimicrobial textiles. J. Ind. Text. 2019, 48, 1113–1135. [Google Scholar] [CrossRef]
- Kathiravan, M.K.; Salake, A.B.; Chothe, A.S.; Dudhe, P.B.; Watode, R.P.; Mukta, M.S.; Gadhwe, S. The biology and chemistry of antifungal agents: A review. Bioorganic Med. Chem. 2012, 20, 5678–5698. [Google Scholar] [CrossRef] [PubMed]
- Arciola, C.; An, Y.; Campoccia, D.; Donati, M.; Montanaro, L. Etiology of Implant Orthopedic Infections: A Survey on 1027 Clinical Isolates. Int. J. Artif. Organs 2005, 28, 1091–1100. [Google Scholar] [CrossRef] [PubMed]
- Formosa-Dague, C.; Feuillie, C.; Beaussart, A.; Derclaye, S.; Kucharíková, S.; Lasa, I.; Van Dijck, P.; Dufrêne, Y.F. Sticky Matrix: Adhesion Mechanism of the Staphylococcal Polysaccharide Intercellular Adhesin. ACS Nano 2016, 10, 3443–3452. [Google Scholar] [CrossRef]
- Ong, Y.-L.; Razatos, A.; Georgiou, G.; Sharma, M.M. Adhesion Forces between E. coli Bacteria and Biomaterial Surfaces. Langmuir 1999, 15, 2719–2725. [Google Scholar] [CrossRef]
- Mai-Prochnow, A.; Clauson, M.; Hong, J.; Murphy, A.B. Gram positive and Gram negative bacteria differ in their sensitivity to cold plasma. Sci. Rep. 2016, 6, 38610. [Google Scholar] [CrossRef] [PubMed]
- Metcalf, W.W.; Van Der Donk, W.A. Biosynthesis of Phosphonic and Phosphinic Acid Natural Products. Annu. Rev. Biochem. 2009, 78, 65–94. [Google Scholar] [CrossRef] [PubMed]
- Rodriguez, J.B.; Gallo-Rodriguez, C. The Role of the Phosphorus Atom in Drug Design. ChemMedChem 2018, 14, 190–216. [Google Scholar] [CrossRef]
- El-Mongy, M.A.; El-Ghany, T.A. Field and laboratory studies for evaluating the toxicity of the insecticide Reldan on soil fungi. Int. Biodeterior. Biodegradation 2009, 63, 383–388. [Google Scholar] [CrossRef]
- Burden, R.S.; Cooke, D.T.; Hargreaves, J.A. Review-mechanism of action of herbicidal and fungicidal compounds on cell membranes. Pestic. Sci. 1990, 30, 125–140. [Google Scholar] [CrossRef]
- Casida, J.E. Organophosphorus Xenobiotic Toxicology. Annu. Rev. Pharmacol. Toxicol. 2017, 57, 309–327. [Google Scholar] [CrossRef]
- Tajti, Á.; Keglevich, G. The importance of organophosphorus compounds as biologically active agents. In Organophosphorus Chemistry-Novel Developments; György Keglevich; Walter De Gruyter: Berlin, Germany, 2018; pp. 53–65. [Google Scholar] [CrossRef]
- Waaijers, S.L.; Hartmann, J.; Soeter, A.M.; Helmus, R.; Kools, S.A.E.; de Voogt, P.; Admiraal, W.; Parsons, J.R.; Kraak, M.H.S. Toxicity of new generation flame retardants to Daphnia magna. Sci. Total Environ. 2013, 463–464. [Google Scholar] [CrossRef] [PubMed]
- Liu, M.; Yin, H.; Chen, X.; Yang, J.; Liang, Y.; Zhang, J.; Yang, F.; Deng, Y.; Lu, S. Preliminary ecotoxicity hazard evaluation of DOPO-HQ as a potential alternative to halogenated flame retardants. Chemosphere. 2018, 193, 126–133. [Google Scholar] [CrossRef] [PubMed]

Publisher’s Note: MDPI stays neutral with regard to jurisdictional claims in published maps and institutional affiliations. |
© 2021 by the authors. Licensee MDPI, Basel, Switzerland. This article is an open access article distributed under the terms and conditions of the Creative Commons Attribution (CC BY) license (http://creativecommons.org/licenses/by/4.0/).
Share and Cite
Vasiljević, J.; Štular, D.; Kalčíková, G.; Zajc, J.; Šobak, M.; Demšar, A.; Tomšič, B.; Simončič, B.; Čolović, M.; Šelih, V.S.; et al. New Insights into Antibacterial and Antifungal Properties, Cytotoxicity and Aquatic Ecotoxicity of Flame Retardant PA6/DOPO-Derivative Nanocomposite Textile Fibers. Polymers 2021, 13, 905. https://doi.org/10.3390/polym13060905
Vasiljević J, Štular D, Kalčíková G, Zajc J, Šobak M, Demšar A, Tomšič B, Simončič B, Čolović M, Šelih VS, et al. New Insights into Antibacterial and Antifungal Properties, Cytotoxicity and Aquatic Ecotoxicity of Flame Retardant PA6/DOPO-Derivative Nanocomposite Textile Fibers. Polymers. 2021; 13(6):905. https://doi.org/10.3390/polym13060905
Chicago/Turabian StyleVasiljević, Jelena, Danaja Štular, Gabriela Kalčíková, Janja Zajc, Matic Šobak, Andrej Demšar, Brigita Tomšič, Barbara Simončič, Marija Čolović, Vid Simon Šelih, and et al. 2021. "New Insights into Antibacterial and Antifungal Properties, Cytotoxicity and Aquatic Ecotoxicity of Flame Retardant PA6/DOPO-Derivative Nanocomposite Textile Fibers" Polymers 13, no. 6: 905. https://doi.org/10.3390/polym13060905
APA StyleVasiljević, J., Štular, D., Kalčíková, G., Zajc, J., Šobak, M., Demšar, A., Tomšič, B., Simončič, B., Čolović, M., Šelih, V. S., & Jerman, I. (2021). New Insights into Antibacterial and Antifungal Properties, Cytotoxicity and Aquatic Ecotoxicity of Flame Retardant PA6/DOPO-Derivative Nanocomposite Textile Fibers. Polymers, 13(6), 905. https://doi.org/10.3390/polym13060905

